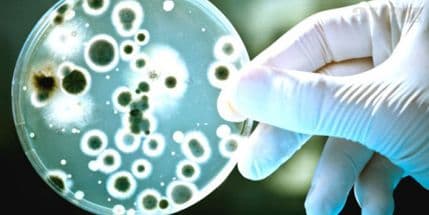
U Italiji hospitalizovan prvi pacijent zaražen koronavirusom U Italiji hospitalizovan prvi pacijent zaražen koronavirusom

U saopštenju se navodi da je pacijent u dobrom stanju i da je pod nadzorom u izolaciji, prenosi Klix ba. Primljen je u bolnicu u Toskani sa visokom temperaturom, kašljem i otežanim disanjem.
On je nedavno proveo 40 dana u Jordanu, gdje je jedan od njegovih sinova obolio od gripe.
Prema podacima Svjetske zdravstvene organizacije, Saudijska Arabija najteže je pogođena novim virusom, jer je u toj zemlji do sada 39 ljudi oboljelo, a 25 je umrlo.
Novi virus prvi put je primijećen polovinom 2012. godine.
Taj virus je srodnik sa virusom koji uzrokuje teški akutni respiratorni sindrom SARS, koji se prije deset godina pojavio i izazvao strahovanja u istočnoj Aziji, jer je prelazio sa životinja na ljude.